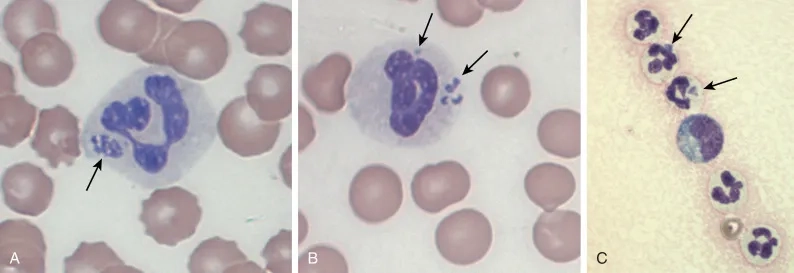
A vet with antibiotics for anaplasmosis in dogs

Protect yourself from the hidden dangers of the outdoors! Anaplasmosis, a serious tick-borne illness, demands your attention. Knowing how to identify and prevent this disease is vital for safeguarding your health, especially if you enjoy hiking or spending time in wooded areas.
What are the main causes of Anaplasmosis?
- Anaplasmosis is primarily caused by the bacterium Anaplasma phagocytophilum, which infects white blood cells.
- The disease is transmitted to humans through the bite of infected blacklegged ticks (also known as deer ticks) or western blacklegged ticks.
- Ticks acquire the bacteria by feeding on infected animals, such as deer and small rodents, then pass it on to humans.

Key symptoms of Anaplasmosis to watch for
- Initial symptoms often include fever, headache, muscle aches, and malaise, typically appearing 1-2 weeks after a tick bite.
- Some individuals may experience chills, nausea, vomiting, diarrhea, and loss of appetite, making diagnosis challenging without specific tests.
- In severe cases, Anaplasmosis can lead to complications like respiratory failure, bleeding problems, or organ damage, necessitating prompt medical attention.
How can you prevent Anaplasmosis effectively?
- When outdoors, use EPA-registered insect repellents containing DEET, picaridin, or oil of lemon eucalyptus on exposed skin and clothing.
- Wear long-sleeved shirts and long pants tucked into socks when in wooded or grassy areas to minimize skin exposure to ticks.
- Perform thorough tick checks on yourself, children, and pets after returning indoors, paying close attention to hair, ears, and skin folds.
>>> Read more here: Rubella vs. Measles: A Simple Guide to German Measles
Images visual examples of anaplasmosis

>>> See this article: Tuberculosis Signs: Don't Ignore This Persistent Cough
Don't let ticks put your health at risk. By taking proactive prevention steps and being aware of the symptoms, you can significantly reduce your chances of contracting Anaplasmosis. Consult your doctor if you suspect a tick-borne illness.
>>> See more: Strep Throat Signs: When Is a Sore Throat More Serious?




